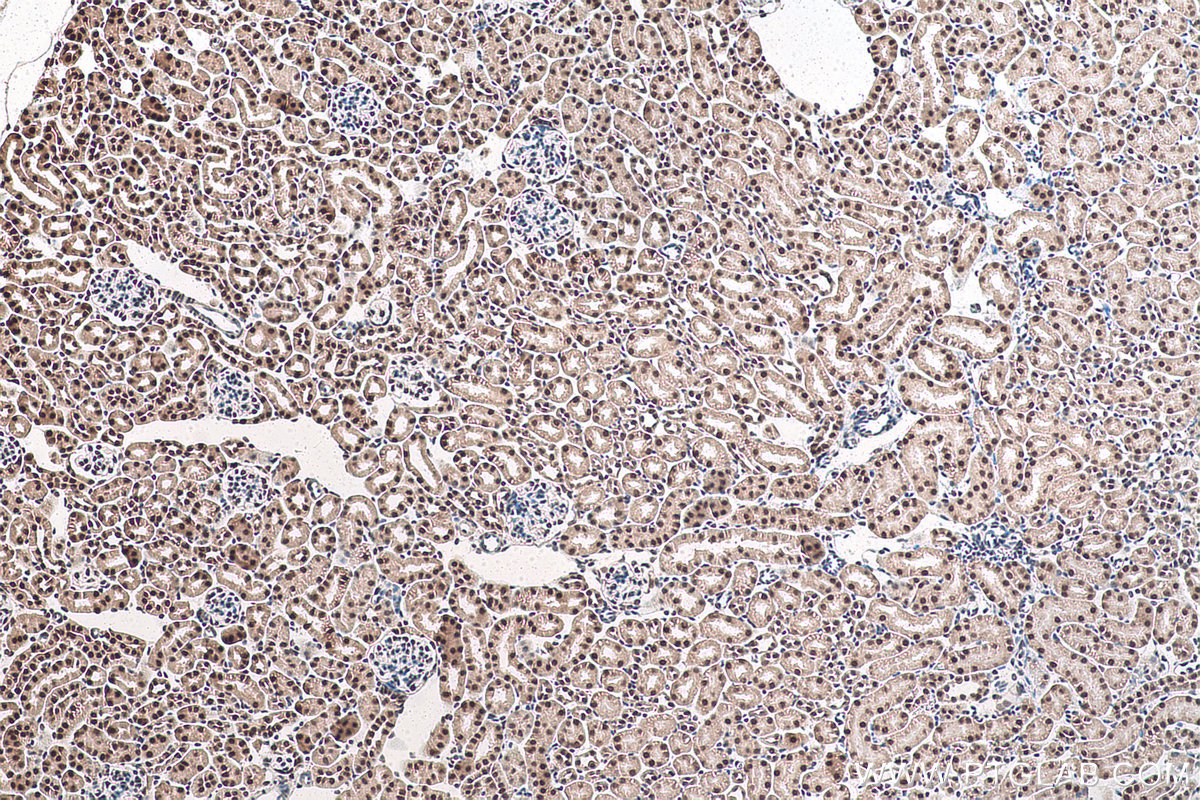

IHCeasy® POLR2E/RPB5 Ready-To-Use IHC Kit
POLR2E/RPB5 Ready-to-use reagent kit for IHC.
Reactivity
Human, Mouse, Rat
Sample Type
FFPE tissue
Cat no : KHC0929
Synonyms
hRPB25, hsRPB5, POLR2E, RPABC1, RPB5, RPB5 homolog, XAP4
Validation Data Gallery
Product Information
KHC0929 is a ready-to-use IHC kit for staining of POLR2E/RPB5. The kit provides all reagents, from antigen retrieval to cover slip mounting, that require little to no diluting or handling prior to use. Simply apply the reagents to your sample slide according to the protocol and you're steps away from obtaining high-quality IHC data.
| Product name | IHCeasy POLR2E/RPB5 Ready-To-Use IHC Kit |
| Sample type | FFPE tissue |
| Assay type | Immunohistochemistry |
| Primary antibody type | Rabbit Polyclonal |
| Secondary antibody type | Polymer-HRP-Goat anti-Rabbit |
| Reactivity | Human, Mouse, Rat |
Kit components
| Component | Size | Concentration |
|---|---|---|
| Antigen Retrieval Buffer | 100 mL | 50× |
| Washing Buffer | 100 mL ×2 | 20× |
| Blocking Buffer | 5 mL | RTU |
| Primary Antibody | 5 mL | RTU |
| Secondary Antibody | 5 mL | RTU |
| Chromogen Component A | 0.2 mL | RTU |
| Chromogen Component B | 4 mL | RTU |
| Signal Enhancer | 5 mL | RTU |
| Counter Staining Reagent | 5 mL | RTU |
| Mounting Media | 5 mL | RTU |
| Datasheet | 1 Copy | |
| Manual | 1 Copy |
Background Information
DNA-dependent RNA polymerase catalyzes the transcription of DNA into RNA using the four ribonucleoside triphosphates as substrates. Common component of RNA polymerases I, II and III which synthesize ribosomal RNA precursors, mRNA precursors and many functional non-coding RNAs, and small RNAs, such as 5S rRNA and tRNAs, respectively. polymerase (RNA) II is the central component of the basal RNA polymerase II transcription machinery. Pols are composed of mobile elements that move relative to each other. In Pol II, POLR2E (Polymerase (RNA) II (DNA directed) polypeptide E) /RPB5 is part of the lower jaw surrounding the central large cleft and thought to grab the incoming DNA template. Seems to be the major component in this process.
Properties
| Storage Instructions | All the reagents are stored at 2-8°C. The kit is stable for 6 months from the date of receipt. |
| Synonyms | hRPB25, hsRPB5, POLR2E, RPABC1, RPB5, RPB5 homolog, XAP4 |